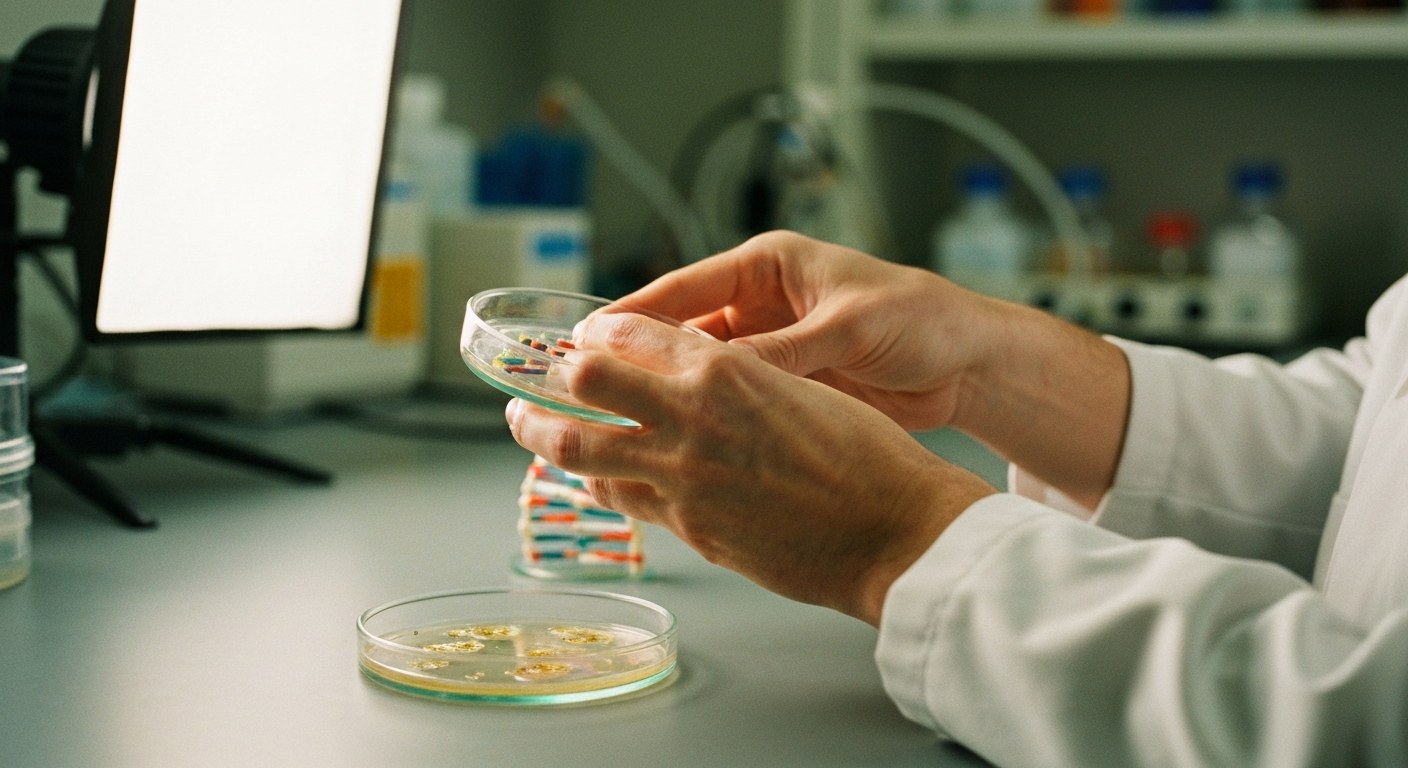
Vědec drží model DNA a Petriho misku při výzkumu genetické predispozice

Celiakie: Kompletní průvodce 2026 – od diagnózy po bezlepkový životní styl

Věděli jste, že až 70 % lidí s celiakií v Česku o své nemoci nevísource? Mnoho z nich žije roky bez správné diagnózy a přitom se jim postupně poškozují střeva. Pokud máte podezření na glutenovou intoleranci nebo vám lékař doporučil vyšetření na celiakii, jste na správném místě. V tomto průvodci se dozvíte vše o příznacích, diagnostice a bezlepkové dietě, která je jedinou možnou léčbou.

Obsah
- Co je celiakie? Definice, příčiny a imunitní mechanismus
- Genetická predispozice: HLA-DQ2 a HLA-DQ8
- Diagnostika celiakie: od krevních testů k biopsii
- Příznaky celiakie: střevní a mimostřevní projevy u dospělých i dětí
- Bezlepková dieta: kompletní seznam potravin a náhradní obiloviny
- Čtení etiket: E-čísla, skryté zdroje lepku a běžné úskalí
- Příspěvky pojišťoven 2026 a podpůrné zdroje pro celiaky
- Rizika neléčené celiakie a proč je důležitá včasná diagnostika
- Často kladené otázky
- Co je to celiakie a jak se liší od alergie na lepek?
- Jaké jsou první příznaky celiakie u dospělých?
- Dědí se celiakie? Kdo by měl podstoupit genetický test?
- Jak probíhá diagnostika celiakie – jaké testy jsou potřeba?
- Co mohou jíst celiaci? Jaké obiloviny jsou bezlepkové?
- Jaký je rozdíl mezi celiakií a neceliakální glutenovou senzitivitou?
- Kolik činí příspěvek pojišťovny na bezlepkovou dietu v roce 2026?
- Může celiakie zmizet bez léčby, nebo je celoživotní?
- Shrnutí a další kroky
- Komunitní tipy
Co je celiakie? Definice, příčiny a imunitní mechanismus
Celiakie je celoživotní autoimunitní onemocnění střev. Vyvolává ji konzumace glutenu – bílkoviny obsažené v pšenici, ječmeni a žitu. U geneticky predisponovaných jedinců spouští gluten imunologickou reakci, při které imunitní systém omylem napadá vlastní tkáň tenkého střeva. Na rozdíl od potravinové intolerance nebo alergie nejde o stav, který byste mohli „vyléčit“ – jedinou cestou, jak příznaky zvládat, je striktní bezlepková dieta. Nejnovější výzkum z Nature navíc ukazuje, že i samotná střevní mikrobiota může hrát roli v tom, jak tělo na gluten reaguje.
Proč se celiakie nedá vyléčit
Při vystavení lepku imunitní systém lidí s celiakií produkuje specifické protilátky proti enzymu tkáňové transglutamináze (anti-tTG). Tyto protilátky jsou klíčovým markerem při diagnostice onemocnění. Vilózní atrofie – tedy zkrácení a poškození střevních klků v tenkém střevě – je přímým důsledkem této imunitní odpovědi. Klky jsou však nezbytné pro vstřebávání živin, a proto jejich poškození vede ke střevní malabsorpci (diagnóza K90.0 dle Mezinárodní klasifikace nemocí). Jelikož jsou střevní klky trvale změněny a genetická predispozice přetrvává celý život, celiaci musí dodržovat bezlepkovou dietu neustále.
Rozdíl mezi alergií na lepek a celiakií
Mnoho lidí zaměňuje celiakii s alergií na lepek, ale jde o odlišné stavy. Alergie na lepek vyvolává okamžitou imunitní reakci zprostředkovanou IgE protilátkami, podobně jako jiné potravinové alergie. Celiakie naopak způsobuje zpožděnou imunologickou reakci s tvorbou anti-tTG protilátek. Ty dlouhodobě poškozují tenké střevo. Zatímco alergie může v průběhu času ustoupit, celiakie je trvalá a vyžaduje doživotní úpravu jídelníčku.
Pochopení imunitního mechanismu nás přivádí k otázce, kdo je vůbec náchylný k rozvoji tohoto onemocnění.
Genetická predispozice: HLA-DQ2 a HLA-DQ8
Mnoho lidí se mylně domnívá, že přítomnost genů HLA-DQ2 nebo HLA-DQ8 automaticky znamená propuknutí nemoci. Tyto geny jsou však nezbytnou, nikoliv postačující podmínkou pro vznik celiakie. Podle současných výzkumů přibližně 30 % populace tyto geny nesesource, ale pouze 1 % z nich skutečně onemocní. To znamená, že samotná přítomnost genu neznamená verdikt – rozhodující roli hrají další faktory, jako je střevní mikrobiom, infekce či expozice lepku.
Kdy podstoupit genetický test
Pokud máte pochybnosti o své predispozici, genetické testování vám poskytne cenné informace. Test je vhodný zejména v případech, kdy se v rodině již celiakie vyskytuje, nebo když máte neurčité příznaky, které by mohly souviset s touto nemocí. Negativní výsledek s 99% přesností vylučuje celiakiisource jako příčinu vašich potíží. Pozitivní výsledek vás naopak řadí mezi rizikovou skupinu a může být podnětem k dalšímu sledování.
Rodinný screening – koho testovat
Rodinný výskyt výrazně zvyšuje pravděpodobnost onemocnění. Pokud je celiakie diagnostikována u jednoho člena rodiny, doporučuje se otestovat i ostatní rodinné příslušníky, zejména rodiče, sourozence a děti. Včasné odhalení predispozice umožňuje sledovat zdravotní stav a předejít komplikacím spojeným s neléčenou celiakií. Více informací o nejnovějších výzkumech najdete v přehledu od Nature.
Genetická predispozice však není vše – pokud máte podezření na onemocnění, je třeba projít konkrétními diagnostickými kroky.
Diagnostika celiakie: od krevních testů k biopsii
Pokud má váš lékař podezření na celiakii, diagnostický proces obvykle začíná krevním testem. Sérologické testy odhalují specifické protilátky proti tkáňové transglutamináze (anti-tTG) a protilátky anti-EMA, které se vytvářejí jako reakce na konzumaci lepku. Tyto testy jsou neinvazivní a představují první krok k potvrzení diagnózy. Výhodou je, že výsledky jsou často dostupné během několika dnů.
Příprava na vyšetření
Před samotným odběrem krve není nutná žádná speciální příprava – testy lze provést kdykoliv během dne. Důležité je, abyste před vyšetřením konzumovali běžnou stravu s lepkem, jinak mohou být výsledky falešně negativní. Pokud jsou výsledky pozitivní, lékař vám doporučí další postup, kterým je obvykle biopsie tenkého střeva. Ta slouží k definitivnímu potvrzení poškození klků a vyloučení jiných příčin obtíží. U dětí podle ESsCD guidelines 2026 existují určité výjimkysource. Lékaři mohou stanovit diagnózu i bez biopsie. Stačí velmi vysoké hodnoty protilátek a jasná genetická predispozice.
Co očekávat při endoskopii
Endoskopie neboli gastroskopie je ambulantní zákrok, při kterém lékař zavede tenkou hadičku s kamerou ústy do duodena – první části tenkého střeva. Před výkonem dostanete lehkou sedaci, takže většinu procedury vůbec nepocítíte. Během endoskopie lékař odebere minimálně čtyři vzorky sliznice z různých částí duodena, protože poškození nemusí být rovnoměrné. Biopsie je klíčová pro posouzení stupně malabsorpce živin a stanovení diagnózy celiakie.
- Sérologický test (anti-tTG a EMA) – rychlý a nenáročný první krok
- Pozitivní výsledek → doporučení k biopsii tenkého střeva
- Endoskopie s odběrem minimálně 4 vzorků z různých částí duodena
- Histologické vyšetření vzorků a stanovení diagnózy
Jedním z důvodů, proč je včasná diagnostika tak důležitá, je i malabsorpce živin, která při neléčené celiakii vede k deficienci železa, vápníku, vitamínu B12 a D. Tito pacienti pak často trpí únavou, osteoporózou nebo neurologickými potížemi. Moderní diagnostika vám proto umožní zahájit bezlepkovou dietu včas a předejít těmto komplikacím dříve, než se prohlubují.
Diagnostika je klíčová proto, že příznaky celiakie mohou být velmi rozmanité a někdy i nečekané.
Příznaky celiakie: střevní a mimostřevní projevy u dospělých i dětí
Projevy celiakie jsou stejně rozmanité jako samotní pacienti. Někteří lidé zažívají klasické střevní potíže. Patří mezi ně průjem, nadýmání, křeče v břiše či neúmyslné hubnutí. Jiní nemají žádné zažívací problémy. Trpí ale celou řadou mimostřevních příznaků celiakie. Lékaři je někdy obtížně spojují s touto diagnózou.
Mimostřevní projevy
- Dermatitida herpetiformis – svědivá, puchýřkovitá vyrážka, která se typicky objevuje symetricky na loktech, kolenou nebo hýždích. Tato kožní forma celiakie přímo souvisí s příjmem lepku a často se objevuje i bez viditelných střevních příznaků.
- Anémie z nedostatku železa nebo vitamínu B12 – projevuje se únavou, bledostí a dušností.
- Osteoporóza – úbytek kostní hmoty způsobený špatným vstřebáváním vápníku a vitamínu D.
- Chronická únava, která neustupuje ani po odpočinku.
Neurologické projevy
- Glutenová ataxie – závažné neurologické onemocnění způsobující problémy s koordinací pohybu, rovnováhou a řečí, které může vést k trvalým následkům při neléčené celiakii.
- Periferní neuropatie – brnění, necitlivost nebo slabost v rukou a nohou.
Reprodukční potíže
- Neplodnost u mužů i žen spojená s neléčenou celiakií.
- Menstruační nepravidelnosti nebo absentní menstruace.
- Opakované potraty.
Jak rozpoznat celiakii u dětí
U dětí se příznaky často projevují odlišně. Kromě zažívacích potíží si lze všimnout poruchy růstu, opožděného vývoje nebo behaviorálních změn – podrážděnosti, úzkosti či problémů s koncentrací. Někdy se celiakie u dětí projevuje pouze nechutenstvím nebo bolestmi břicha bez průjmu. Včasné rozpoznání je klíčové pro správný vývoj dítěte.
Nejčastější maskované příznaky
- Únava, která se přisuzuje přetížení nebo stresu.
- Opakované afty nebo bolestivé klouby.
- Anémie bez zjevné příčiny.
Pokud se vás týká některý z těchto příznaků, zvažte návštěvu lékaře. Nechte se otestovat na celiakii ještě předtím, než si sami nasadíte eliminační dietu. Předejdete tak zkreslení výsledků.
Potvrzení diagnózy znamená zásadní změnu v jídelníčku – pojďme se podívat, co všechno můžete jíst.
Bezlepková dieta: kompletní seznam potravin a náhradní obiloviny
Přechod na bezlepkovou dietu znamená především pochopení, kterým obilovinám se vyhnout. Zakázaných je pět hlavních kategorií: pšenice, ječmen, žito, špalda a kamut. Pozor také na běžný oves – ten je problematický ne svou vlastní bílkovinou, ale rizikem kontaminace při zpracování. Řešením je certifikovaně bezlepkový oves, který prošel speciální úpravou a testováním. Podle aktuálních výzkumů na Nature je dodržování přísné bezlepkové diety jediným ověřeným způsobem léčby pro pacienty s celiakií.
Základní nákupní seznam pro celiaci
Přírodně bezlepkové obiloviny jsou vaším novým základem. Quinoa, amarant, pohanka, proso, čirok a teff nabízejí skvělou texturu a nutriční hodnoty. Oblíbená je i pohanka, která má jemnou oříškovou chuť a hodí se do kaší či nádivek. Kromě obilovin smíte bez obav konzumovat luštěniny, ořechy, semena, čerstvé maso, ryby, vejce, zeleninu i ovoce. Při nákupech vám pomohou certifikační značky – symbol přeškrtnutého klasu na obalu garantuje obsah pod 20 mg/kg.

Pomůcky do kuchyně: jak předejít kontaminaci
Domácnost s celiakem vyžaduje speciální režim i v kuchyni. Křížová kontaminace je záludná – může vzniknout na prkénku po krájení pečiva, v hrnci, kde se vařila běžná pasta, nebo ve fritéze s nebezpečným olejem. Pořiďte si samostatnou sadu nádobí a náčiní označenou barevnou páskou, aby nedošlo k záměně. Nezapomínejte ani na kuchyňské utěrky a povrchy – mohou uchovávat stopy mouky. Informace o příspěvcích pojišťoven na bezlepkové potraviny najdete na CeliakShop.cz.
Při nákupech však musíte být obezřetní i u zdánlivě bezpečných produktů – lepek se může skrývat na mnoha místech.
Čtení etiket: E-čísla, skryté zdroje lepku a běžné úskalí
| Rizikový přídavek | Co hledat na etiketě | Proč je rizikový |
|---|---|---|
| E150d – karamel amoniakový | Označení „karamel amoniakový“ nebo „E150d“ | Může pocházet z ječmene, který obsahuje lepek. Najdete ho v některých omáčkách, polévkách a uzeninách. |
| E636, E640 – hydrolyzované bílkoviny | „Hydrolyzované bílkoviny“, „hydrolyzované rostlinné bílkoviny“ | Tyto E-čísla označují skryté zdroje lepku, které nebývají na první pohled viditelné. Výroba je často odvozuje z pšenice nebo ječmene. |
| Modifikovaný škrob, pšeničný škrob | Složení na zadní straně balení | I malé množství může vyvolat reakci u citlivých jedinců. Nikdy nevsázejte na to, že „škrob“ automaticky znamená bezlepkový. |
Seznam rizikových E-čísel
Při čtení etiket si poznamenejte tato E-čísla: E150d, E636, E640, ale i E1404, E1410, E1412, E1413, E1414 a E1420. Všechna pocházejí z obilovin obsahujících lepek. Výrobci je chemicky upravují z pšeničného škrobu. Výrobci je musí uvádět, ale ne vždy zvýrazňují jejich původ. Ideální je mít po ruce aplikaci pro skenování etiket nebo ověřenou databázi bezlepkových produktů, která vám ušetří čas při nákupu potravin bezpečných pro celiaky.
Jak správně číst etikety v obchodě
Každý výrobek si důkladně prohlédněte, i když jste ho kupovali opakovaně. Receptury se mění. Varovné nápisy jako „může obsahovat stopy lepku“ nebo „vyrobeno ve stejné provozovně jako výrobky obsahující lepek“ jsou sice nepovinné, ale ostražitost je na místě. Pokud si nejste jistí, zkuste kontaktovat výrobce – většina firem na dotazy o složení odpovídá. Prevence se vyplatí víc než pozdější zdravotní komplikace.
Kromě pečlivého nakupování můžete jako celiak využít i finanční podporu od zdravotních pojišťoven.
Příspěvky pojišťoven 2026 a podpůrné zdroje pro celiaky
Ročně můžete získat až 6 000 Kč na bezlepkové potraviny díky příspěvku od České průmyslové zdravotní pojišťovny. Tato podpora se vztahuje na pacienty s diagnózou K90.0 a platí pro děti i dospělé bez věkového omezení. Nejste v tom sami – existuje síť zdrojů, které vám pomohou zvládnout bezlepkovou dietu v praxi při celiakii.
Jak požádat o příspěvek krok za krokem
Abyste mohli čerpat příspěvek na bezlepkovou dietu, potřebujete nejprve potvrzení od svého lékaře, že máte celiakii. S touto dokumentací pak podáte žádost přímo u své pojišťovny. ESsCD guidelines 2026 doporučují multidisciplinární přístup, což znamená, že lékař by měl spolupracovat s nutričním specialistou při sestavování vašeho jídelníčku.
Kde hledat podporu a komunitu
Poradna pro celiaky na celiaci.cz nabízí odborné konzultace. Specialisté vám poradí s každodenními výzvami bezlepkové diety. Mnoho pacientů doporučuje také kurzy bezlepkového pečení – setkali jste se s nějakými ve vašem okolí? Kromě praktických dovedností získáte přístup ke komunitě, která sdílí recepty a zkušenosti. Podle ESsCD 2026 guidelines je dlouhodobé sledování zdravotního stavu klíčové pro prevenci komplikací.
Finanční příspěvky jsou vítanou pomocí, ale důležitější je pochopit, proč neléčená celiakie představuje vážné zdravotní riziko.
Rizika neléčené celiakie a proč je důležitá včasná diagnostika
Mnoho lidí si myslí, že mírné zažívací potíže nejsou důvodem k návštěvě lékaře. Jenže neléčená celiakie má dalekosáhlé důsledky pro celé tělo. Při celoživotní konzumaci lepku se střevní sliznice neustále zanícuje. Tento zánět vede k malabsorpci živin. Tělo jednoduše nedokáže vstřebat dostatek vitaminu D, B12 ani železa. Výsledkem je často chronická anémie, únava a oslabení imunity. Odborníci z Akademie věd upozorňují, že u dospělých mohou příznaky pocházet z trávicího traktu nebo se projevovat mimo něj, což diagnózu ztěžuje.
Proč nepodceňovat mírné příznaky
I když pociťujete jen mírné nadýmání nebo občasnou únavu, vaše tělo může reagovat na lepek zánětlivou reakcí, která poškozuje střevní klky. Právě to je důvod, proč se při delším neléčení zvyšuje riziko osteoporózy. Vápník se bez funkčních klků vstřebává obtížně. U žen může neléčená celiakie vést k neplodnosti nebo komplikacím v těhotenství. Existuje také zvýšené riziko rozvoje některých nádorových onemocněnísource, zejména při dlouhodobé expozici lepku bez jakékoli léčby.
Dlouhodobý monitoring po diagnostice
Po nasazení bezlepkové diety dochází k regeneraci střevní sliznice během 3–6 měsícůsource – v závislosti na tom, jak dlouho byla sliznice poškozena. PharmDr. Margit Slimáková však varuje před samostatným odstraněním lepku bez lékařského potvrzení diagnózy. Pokud si sami nasadíte dietu a necítíte žádné problémy, můžete získat falešný pocit bezpečí. Bez sledování odborníkem vám však hrozí nutriční deficity. Jíte jiné potraviny a můžete prožívat zbytečný stres z jídla. Bez správné diagnostiky a pravidelných kontrol tak zůstáváte v nebezpečí, i když se snažíte jíst zdravě.
Často kladené otázky
Co je to celiakie a jak se liší od alergie na lepek?
Celiakie je autoimunitní onemocnění, při kterém gluten vyvolává imunitní reakci poškozující sliznici tenkého střeva. Naproti tomu alergie na lepek je reakce zprostředkovaná IgE protilátkami s okamžitými příznaky, jako jsou otoky nebo vyrážka. Podle některých odborníků je třeba tyto stavy pečlivě odlišovat, protože jejich management se liší. Více informací najdete v průvodci celiakií na Margit.cz.
Jaké jsou první příznaky celiakie u dospělých?
Příznaky celiakie u dospělých bývají často netypické a zahrnují únavu, bolesti kloubů, migrény, anémii nebo kožní problémy, jako je dermatitida herpetiformis. Trávicí obtíže se nemusí vyskytovat vůbec, což ztěžuje včasnou diagnózu. Celiakie se proto často označuje jako „velká maskérka“. Zpozorněte, pokud se u vás objeví dlouhodobé zdravotní potíže bez jasné příčiny.
Dědí se celiakie? Kdo by měl podstoupit genetický test?
Celiakie má silnou genetickou složku – v rodinách se vyskytuje častěji než v běžné populaci. Geny HLA-DQ2 a HLA-DQ8 jsou přítomny až u 95 % nemocnýchsource. Genetický test doporučuji především přímým příbuzným celiaců, osobám s jinými autoimunitními onemocněními a pacientům s nejasnými trávicími potížemi. Test vám může pomoci vyloučit nebo potvrdit genetickou predispozici ještě před rozvojem příznaků.
Jak probíhá diagnostika celiakie – jaké testy jsou potřeba?
Diagnostika začíná krevním testem na protilátky tTG-IgA, který slouží jako první screening. Při pozitivním výsledku následuje biopsie tenkého střeva, která potvrdí poškození klků. Podle aktualizovaných evropských guidelines mohou někteří pacienti absolvovat diagnostiku bez biopsie, pokud jsou hladiny protilátek výrazně zvýšené. Kompletní diagnostiku doporučuji konzultovat s poradnou pro celiaky na CeliakShop.cz.
Co mohou jíst celiaci? Jaké obiloviny jsou bezlepkové?
Celiaci mohou bez obav konzumovat rýži, kukuřici, pohanku, quinou, amarant či proso. Naopak pšenice, žito a ječmen obsahují gluten a jsou přísně zakázány. Oves bývá často kontaminován, proto vybírejte výhradně certifikovaný bezlepkový oves. Přechod na bezlepkovou dietu usnadňují rady a tipy pro celiaci na CeliakShop.cz.
Jaký je rozdíl mezi celiakií a neceliakální glutenovou senzitivitou?
Při celiakii imunitní systém produkuje specifické protilátky a poškozuje střevní sliznici. Neceliakální glutenová senzitivita způsobuje podobné obtíže, ale bez těchto markerů a bez viditelného poškození střeva. NCGS proto nemá tak závažné dlouhodobé následky, přesto však vyžaduje bezlepkovou dietu. Přesnou diagnózu rozhodně svěřte odborníkům z Akademie věd.
Kolik činí příspěvek pojišťovny na bezlepkovou dietu v roce 2026?
V roce 2026 poskytují české pojišťovny příspěvky na bezlepkovou dietu v rozmezí 3 000 až 6 000 Kč ročně, v závislosti na konkrétní pojišťovně. Například ČPZP nabízí až 6 000 Kč ročně bez věkového omezení. Příspěvek lze čerpat na certifikované bezlepkové produkty zaregistrovaných prodejců. Podmínky a aktuální nabídku ověřte na stránce příspěvků pojišťoven na CeliakShop.cz.
Může celiakie zmizet bez léčby, nebo je celoživotní?
Celiakie je celoživotní onemocnění – po vysazení bezlepkové diety se příznaky vždy vracejí a poškození střeva pokračuje. Bez léčby hrozí závažné komplikace, včetně osteoporózy, neplodnosti nebo lymfomu. I když se některým pacientům daří být dlouhodobě bez příznaků, návrat k běžné stravě není možný. Nejnovější poznatky o mechanismech celiakie zkoumá výzkum na Nature.com.
Shrnutí a další kroky
Celiakie je celoživotní autoimunitní onemocnění, které vyžaduje přísné dodržování bezlepkové diety. Klíčové je včasné rozpoznání příznaků a diagnostika – neléčená celiakie může vést k závažným zdravotním komplikacím. I nepatrné množství lepku dokáže způsobit poškození střevní sliznice.
Při podezření na celiakii se obraťte na svého lékaře, který vám doporučí vhodná vyšetření. Informujte se u své pojišťovny o příspěvcích na bezlepkové potraviny a využijte dostupné podpůrné zdroje. Život s celiakií je zvládnutelný díky správným informacím, kvalitním potravinám a podpoře odborníků.






